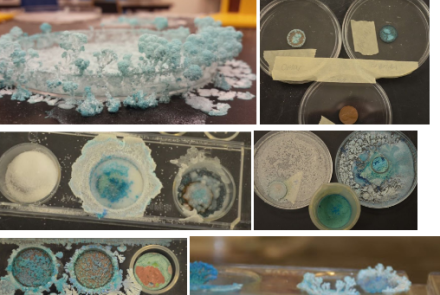
oxidize a copper penny science lab

States of Matter Video: What does it really mean to be a solid, liquid or gas?
In this science video, Veritasium does a fantastic job interviewing the public to see if they know what it actually means to be a solid, liquid or a gas. It is fun to watch people try to remember from their schooling what the scientific answer is. This would be a great video to show when introducing 3 of the 4 states of matter to your chemistry or physical science students.